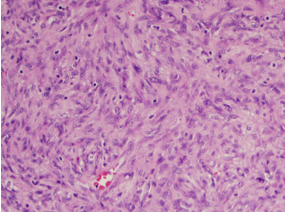
Mixed spindle cells with foci of epitheliod tissues. Mitotic rate of 7/50 HPF.

Incidental Finding of a Gastrointestinal Stromal Tumor during an Inguinal Hernia Repair.
- 1. Department of General Surgery, Geisinger Medical Center, USA
Abstract
Gastrointestinal Stromal Tumors (GISTs) are rare tumors derived from the mesenchyme. They are usually benign and are most commonly found in the stomach. They arise from the interstitial cells of Cajal, and the majority express c-kit, a tyrosine kinase receptor. Only about a third of patients with GIST have symptoms. There have been several reports of GIST found incidentally during gastric bypass surgery. However, there is a paucity of literature regarding GISTs found incidentally during other types of operations.
Case presentation: A 53-year old male was referred to the general surgery clinic for bilateral inguinal hernias. A bilateral inguinal hernia repair with plug and patch mesh was performed. At the time of his operation, a nodule was noted in the right hernia sac and was subsequently sent to pathology. The pathology report revealed a GIST with a high mitotic rate.
Discussion: Most GISTs are symptomatic or found incidentally on CT (computerized tomography) scans. This is an interesting case because previous literature regarding GIST found incidentally at the time of a hernia repair is rare.
Conclusions: A Computerized Tomography and Positron Emission Tomography (CT/PET)scan revealed a large mass in the left upper quadrant of the abdomen that had a necrotic center and involved several loops of small bowel. The patient was placed on Imatinib. A repeat CT/PET scans revealed decrease size in the left upper quadrant mass. This case illustrates the importance of sending tissue to pathology when there are unanticipated findings in the operating room.
Keywords
• Gastrointestinal stromal tumor
• Incidental
• Inguinal hernia
Citation
Campbell R, Hashmi A, Marie Hunsinger RN BSHS, Shabahang M, Blansfield J, et al. (2017) Incidental Finding of a Gastrointestinal Stromal Tumor during an Inguinal Hernia Repair. JSM Gen Surg Cases Images 2(2): 1024.
ABBREVIATIONS
GIST: Gastrointestinal Stromal Tumor; CT: Computed Tomography; CT/PET: Computed Tomography and Positron Emission Tomography; HPF: High Powered Field; AJCC: American Joint Committed on Cancer; NCCN: National Comprehensive Cancer Network
INTRODUCTION
Gastrointestinal Stromal Tumors (GISTs) are rare mesenchymal tumors which account for 0.1-3% of all gastrointestinal malignancies. However, they are the most common sarcoma and account for 80% of all gastrointestinal mesenchymal neoplasms. Median age of diagnosis is 60 years old, and has an increased risk in male and black patients. [1,2]. They are usually slow growing tumors and are most commonly found in the stomach and second most commonly in the small bowel. They arise from the interstitial cells of Cajal, and the majority express c-kit, a tyrosine kinase receptor [3]. This expression helps identify these cells on immune histochemical staining.
Roughly one third of patients with GIST are symptomatic [1]. These symptoms are usually vague and include abdominal pain and anemia [4]. Twenty-two percent of GISTs are found at the time of autopsy [5]. Twenty to thirty percent of patients are found to have GISTs incidentally, usually on computed tomography (CT) scan performed for another indication [4]. There have been several reports of GIST found incidentally during gastric bypass surgery [6,7]. However, there is a paucity of literature regarding GIST found incidentally during other types of operations. Typically, GIST presents as a solitary tumor but these tumors do have the potential to metastasize. They spread hematogenously, as well as directly through seeding of the peritoneum in up to 40- 60% of patients [8,9].
Here we will present the case of a small bowel GIST found incidentally during an inguinal hernia repair due to carcinomatosis in the hernia sac
CASE PRESENTATION
A 53-year old male was referred to the general surgery clinic for a bulge in his right groin. He denied past medical history, and his past surgical history was only significant for an appendectomy. Physical exam revealed a reducible right inguinal hernia in addition to a small left inguinal hernia. An open bilateral inguinal hernia repair with plug and patch mesh was performed electively. At the time of surgery, a nodule was noted in the right hernia sac and the sac with the nodule was subsequently sent to pathology. The final pathology report revealed a GIST on immune histo chemical staining for c-kit, with a high mitotic rate of 7 in a 50 high powered field (Figure 1).
Figure 1 Mixed spindle cells with foci of epitheliod tissues. Mitotic rate of 7/50 HPF.
A computed tomography and positron emission tomography (CT/PET) scan was performed for staging and revealed a large 7.5 by 10 cm mass in the left upper quadrant of the abdomen that had a necrotic center and involved several loops of small bowel (Figure 2).
Figure 2 CT/PET scan showing liver nodule and large left upper quadrant mass with necrotic center.
In addition, the patient had liver nodules, and right lower quadrant abdominal lesions. The patient was seen by oncology and started on Imatinib. Four months after initial diagnoses, a repeat CT/PET scan revealed a decrease in the volume of his disease. He was continued on Imatinib therapy; however, he developed resistance which was evident with tumor growth. He was subsequently switched to Sunitinib therapy, but he was noted to have continued growth and deemed nonresponsive. He was taken to the operating room for tumor cytoreduction 32 months after diagnosis. Heunder went en bloc resection of the left upper quadrant mass involving the splenic flexure of the colon and jejunum with primary jejunal anastomosis. He had tumor nodules involving the right colon, and therefore an extended right hemicolectomy with ileosigmoid anastomosis was performed. He also required resection of segment V of his liver for 3 metastatic nodules. The left upper quadrant tumor on final pathology was 9.5 cm, and the nodules in the right colon and liver were metastatic nodules. He had 2 out of 8 lymph nodes positive. He was then treated with Regorafenib, and will be followed with CT/PET scans.
DISCUSSION
It is extremely rare to find a GIST incidentally at the time of a hernia repair. There have been a few reports of GIST being found incidentally during an inguinal hernia repair. One case reported found a GIST which had herniated through an inguinal hernia and presented with what appeared to be an incarcerated inguinal hernia [10]. In another case a patient presented with a femoral hernia and bowel obstruction. On initial examination, the patient did not appear to be obstructed due to the hernia. This prompted further exploration, which revealed a jejunal mass which was resected and determined to be a GIST [11]. There are also reports of GIST found during bariatric surgery [6,7]. These tumors were all resected successfully, and found to be of low risk for recurrence. Our patient’s primary tumor was not discovered until CT scan after the incidental finding of a metastasis in the hernia sac.
Most GISTs are found to be low risk for malignant potential. It has been reported that roughly 50% of GISTs present with metastatic disease [12]. However, these tumors can still have malignant potential even after being labeled as “benign”. Up to 50% of patients have recurrent disease at 5 years [1,13]. The Fletcher Model (Table 1)
|
Table 1: Fletcher Model. |
|||
|
T-stage |
Tumor size |
Mitosis (50 HPF) |
Fletcher |
|
T1 |
<2 cm |
<5 |
Very Low Risk |
|
5 to 10 |
Intermediate Risk |
||
|
>10 |
High Risk |
||
|
T2 |
2-5 cm |
<5 |
Low Risk |
|
5 to 10 |
Intermediate Risk |
||
|
>10 |
High Risk |
||
|
T3 |
5-10 cm |
<5 |
Intermediate Risk |
|
5 to 10 |
High Risk |
||
|
>10 |
High Risk |
||
|
T4 |
>10 cm |
<5 |
High Risk |
|
>5 |
High Risk |
||
|
Abbreviations: HPF: High Powered Field. |
|||
uses tumor size and mitotic rate to determine the risk for malignant potential [13]. Tumors less than 5 cm with mitotic rate of less than 5 in a 50 high powered field (HPF) are at low risk. Tumors less than 5 cm with a mitotic rate of 5-10 in 50 HPF are at intermediate risk. Tumors greater than 5 cm or with a mitotic rate greater than 10 in a 50 HPF are at a high risk for malignant potential.
The American Joint Committee on Cancer (AJCC) stages GIST by first stratifying location of the tumor [14]. For gastric GIST stage one is any tumor less than 10 cm with a low mitotic rate. Stage 2 is either a tumor greater than 10 cm with a low mitotic rate or a tumor less than 5 cm with a high mitotic rate. Stage 3 is any tumor greater than 5 cm with a high mitotic rate. Stage 4 is any positive lymph nodes or any distant metastasis (Table 2).
|
Table 2: American Joint Committee on Cancer (AJCC) Model. |
|||||
|
AJCC (gastric) |
AJCC (Small intestine) |
T-stage |
Mitosis (50 HPF) |
N-stage |
M-stage |
|
stage IA |
stage I |
T1 |
low |
N0 |
M0 |
|
T2 |
low |
N0 |
M0 |
||
|
stage IB |
stage II |
T3 |
low |
N0 |
M0 |
|
stage II |
stage IIIA |
T4 |
low |
N0 |
M0 |
|
stage II |
stage IIIA |
T1 |
high |
N0 |
M0 |
|
stage II |
stage IIIB |
T2 |
high |
N0 |
M0 |
|
stage IIIA |
stage IIIB |
T3 |
high |
N0 |
M0 |
|
Stage IIIB |
stage IIIB |
T4 |
high |
N0 |
M0 |
|
stage IV |
stage IV |
any T |
N1 |
M0 |
|
|
stage IV |
stage IV |
any T |
any N |
M1 |
|
|
Abbreviations: HPF: High Powered Field |
|||||
While size and mitotic rate are both important in determining malignant potential in GIST, mitotic rate is the most important predictor [3,15]. Metastases usually occur in the liver or peritoneum which was the case in our patient. Our patient also had lymph node metastasis, which is a rare presentation for GIST occurring around 1% of the time [16,17]. The treatment for solitary tumors with a low malignant potential is local resection. For higher malignant potential patients, imatinib is administered adjuvantly based on several studies that show decrease in recurrence [18-20].
Our patient had stage IV disease at the time of his presentation. The best treatment for the primary tumor is still resection. The treatment for metastatic disease or unresectable disease is Imatinib [21]. Our patient, who had unresectable, metastatic disease at the time of presentation, began treatment with Imatinib and initially had a good response to treatment but eventually developed resistance. After developing resistance to Imatinib he was treated with Sunitinib, but unfortunately developed resistance to this as well. At this point he underwent tumor cytoreduction with an en bloc resection of the tumor involving the splenic flexure and proximal jejunum, an extended right hemicolectomy, and liver wedge resection. There have been several studies that have shown benefit for patients to undergo cytoreductive surgery after imatinib therapy and this has been incorporated into the National Comprehensive Cancer Network (NCCN) guidelines [22-24].
It is very unusual to have an incidental finding of carcinomatosis at the time of an inguinal hernia repair. There have been case reports of enlarged lymph nodes found during inguinal hernia repairs, but there is little literature regarding metastatic disease found during an inguinal hernia repair. It is more common for incidental findings to occur at the time of umbilical hernia repairs. Most of the incidental findings during umbilical hernia repairs are metastatic spread of gastrointestinal tract, ovarian, or endometrial cancers [25]. However, there is a case report of a GIST found at the time of an umbilical hernia repair [26]. This case illustrates the importance of sending tissue to pathology when there are unanticipated findings in the operating room. All tissue that is removed during an operation should be inspected closely for abnormalities prior to being sent for pathology.